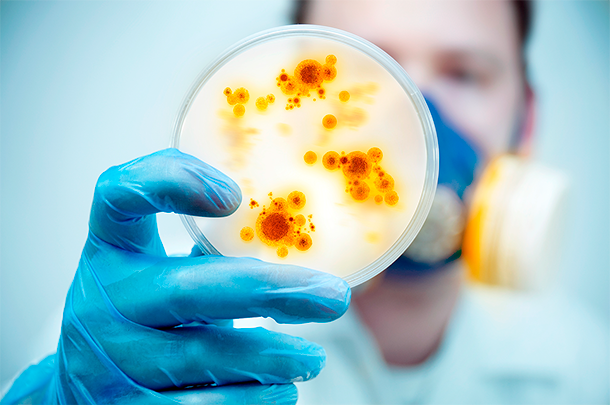

Las infecciones de transmisión sexual (ITS), son una de las causas principales de morbilidad en las personas sexualmente activas.
El virus del papiloma humano (VPH o HPV del inglés human papillomavirus) son grupos diversos de virus ADN pertenecientes a la familia de los Papillomaviridae y representa una de las enfermedades de transmisión sexual más comunes.
La infección por VPH no tiene cura, pero hay muchas cosas que puedes hacer para evitar que el VPH afecte la salud. Hay vacunas para protegerse del contagio de ciertos tipos de VPH. Las infecciones causadas por el VPH de alto riesgo pueden tratarse fácilmente antes de que se conviertan en cáncer, por lo cual es tan importante hacerse las pruebas de Papanicolaou/VPH periódicas.
Existen alrededor de 100 tipos de VPH, pueden ser de bajo riesgo oncogénico, que generalmente se asocian a las lesiones benignas, como verrugas y lesiones de bajo grado, o de alto riesgo oncogénico. Estos tipos de VPH también pueden producir verrugas, pero asocian lesiones precancerosas, que son las lesiones que pueden evolucionar lentamente en cáncer.